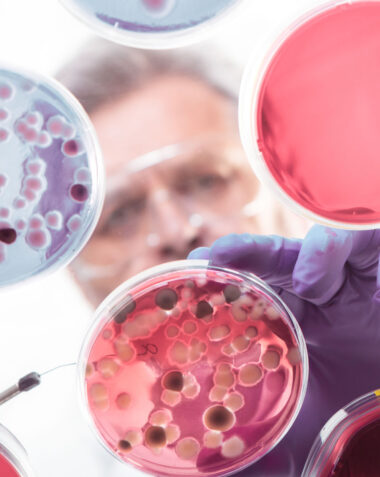

CASE STUDIES
We Don’t Just Advise— We Deliver Measurable Results
Our success is measured by the tangible impact we create for our clients. Here are real examples of how our co-execution methodology has transformed businesses across industries.
Data Center Business Transformation
Transformed struggling data center business through strategic repositioning and operational excellence, doubling valuation from $250M to…
ATM Network Expansion
Won $650M government contract for 7,500 ATMs while optimizing vendor relationships and improving third-party SLA compliance…
Life Sciences Transformation
Transformed loss-making life sciences company into profitable business, doubling revenue through operational restructuring, technology modernization, and…
IT Services Firm Growth
Achieved 2X revenue growth and 3X CAGR through strategic positioning and operational excellence, earning Gartner and…
Startup Success Story
Guided technology startup from concept to market leadership through systematic product-market fit validation, business model development,…